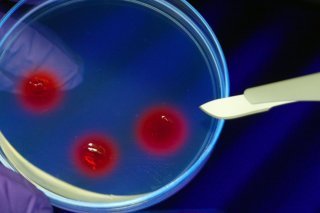
L'idée est de prendre de l'ADN de l'espèce éteinte et de comparer son génome à des espèces modernes proches. Une fois la plus proche sélectionnée, l'outil CRISPR, surnommé ciseaux moléculaires, est utilisé afin d'éditer le génome moderne, là où il...

Une étude montre comment faire revivre une espèce éteinte de rat
Depuis le film Jurassic Park, l'idée de ramener à la vie des espèces éteintes fascine. Une équipe spécialisée dans la paléogénétique a cherché à déterminer la méthode qui permettrait de ressusciter une espèce de rat, le Rattus macleari.
Endémique de l'île Christmas, dans l'océan Indien, cette espèce de rat a disparu il y a environ 120 ans. Les chercheurs ne sont pas allés jusqu'à recréer un spécimen vivant, mais, selon eux, leur étude publiée mercredi dans la revue Current Biology montre à quel point les scientifiques travaillant sur des projets dits de "désextinction" pourraient s'en approcher.
"Je ne fais pas de la désextinction, mais je pense que c'est une idée intéressante et, techniquement, c'est très enthousiasmant", a déclaré à l'AFP l'auteur principal de ces travaux, Tom Gilbert, de l'université de Copenhague.
Trois techniques sont explorées pour ressusciter des animaux disparus: croiser des espèces proches afin de retrouver certains traits perdus, le clonage et, enfin, l'édition génomique. C'est sur cette dernière que se sont penchés Tom Gilbert et ses collègues.
L'idée est de prendre de l'ADN de l'espèce éteinte et de comparer son génome à des espèces modernes proches. Une fois la plus proche sélectionnée, l'outil CRISPR, surnommé ciseaux moléculaires, est utilisé afin d'éditer le génome moderne, là où il diffère de l'ancien. Les cellules ainsi modifiées pourraient ensuite être utilisées pour créer un embryon, à implanter chez une mère porteuse.
Selon Tom Gilbert, l'ADN ancien est comme un livre passé à la broyeuse. Le génome d'une espèce moderne, lui, est le livre de référence, intact, qui peut être utilisé pour déchiffrer les fragments abîmés de son ancêtre.
Les chercheurs ont utilisé des rats bruns, communément présents dans les laboratoires, comme espèce moderne de référence. Ils ont déterminé pouvoir reconstituer 95% du génome du rat de l'île Christmas.
Bien que cette proportion puisse sonner comme un franc succès, les 5% perdus font partie de régions du génome contrôlant l'odorat et le système immunitaire: le rat ressuscité ressemblerait ainsi certainement à l'ancien, mais il lui manquerait certaines fonctions clés.
Ces résultats ont d'importantes implications pour les projets de "désextinction" en cours, comme celui d'une entreprise américaine de faire revivre un mammouth. Les mammouths, éteints il y a environ 4000 ans, sont aussi éloignés des éléphants modernes que le Rattus macleari des rats bruns.
En Australie, une équipe est pour sa part en train de chercher à faire revivre le tigre de Tasmanie, dont le dernier spécimen est mort en captivité en 1936.

